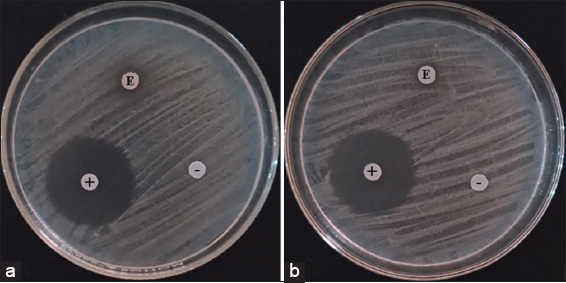

Pycnoporus sanguineus is a bright orange-red colored thin fan-like shaped bracket basidiomycetes. This paper highlights the effects of time-course submerged culture on the growth of mycelia and biological activities of P. sanguineus. Prolonged incubation of mycelia in submerged cultivation using coconut water up to 25 days significantly increased the mycelial biomass from 0.24 g to 0.51 g (dry weight), and correspondingly the biomass concentration from 4.8 g/L to 10.2 g/L. The characteristics of mycelia varied in every period of incubation. The radical scavenging activity of mycelial extracts increased in extending time of incubation, whereas the phenolic content peaked after 20 days of fermentation. Extracts of all ages of mycelia exhibited antibacterial activity against both bacteria, having a zone of inhibition diameter ranges of 8.00–9.30 mm in Staphylococcus aureus and 7.11–7.38 mm in Escherichia coli. Prolonged incubation caused the decrease in LC50 values from 154.83 μg/mL to 16.02 μg/mL after 25 days, indicating an increasing toxicity of the mycelial extracts. The 20-day-old mycelia contain nine groups of fungal chemicals that include triterpenes, flavonoids, tannins, phenols, steroids, alkaloids, anthraquinones, anthrones, and fatty acids, which are responsible to the above-mentioned biological activities. Therefore, prolonged submerged culture of P. sanguineus mycelia up to 25 days enhances the production of mycelial biomass and improves the biological activities.
Mendoza WC, Dulay RMR, Valentino MJG, Reyes RG. Mycelial biomass and biological activities of Philippine mushroom Pycnoporus sanguineus in time-course submerged culture. J App Biol Biotech. 2020;8(05):88-93. DOI: https://dx.doi.org/10.7324/JABB.2020.80512
Mushrooms have been utilized since historic time not only as simple food but also as a natural medicine to treat a wide range of diseases. As nutritious food, mushrooms are rich crude proteins, soluble polysaccharides, dietary fiber, vitamins, and minerals and accumulate a variety of active metabolites, including saponins, flavonoids, alkaloids, anthraquinones, anthrones, phenols, coumarins, fatty acids, and steroids [1,2]. These components of mushrooms are attributed to their biological activities, including hypoglycemic, antibacterial, antioxidant, and teratogenic activities [3-5]. Moreover, they are also responsible for immune system modulation, inflammation inhibition, hypertension and atherosclerosis prevention, antitumor, hypocholesterolemic, hypoglycemic, antithrombotic, and antimicrobial activities of mushrooms [6].
Pycnoporus sanguineus is a bright orange-red colored thin fan-like shaped bracket mushroom that is naturally growing on fallen hardwoods. This mushroom is usually ignored and not utilized by Filipinos. However, in Brazil, some indigenous people use this mushroom to stop hemorrhages [7]. It was also reported that cinnabarin is one of the important secondary metabolites of P. sanguineus that has antibacterial activities and pharmacological properties [8]. However, Borderes et al. [9] revealed that cinnabarin was not the main compound produced by P. sanguineus. Recently, the mycelial growth performance in various solid culture media and the fruiting body production in rice straw-sawdust based substrate were studied (unpublished data) in our aim to establish techniques for its biomass production and popularize the utilization of this mushroom in the Philippines.
Submerged culture is an efficient, fast, and practical technique of producing mycelial biomass of mushroom, especially those that do not successfully produce fruiting bodies or with very low biomass yield under solid-fermentation conditions. Dulay et al. [10] optimized the submerged culture conditions for the production of mycelial biomass of Ganoderma lucidum, Volvariella volvacea, Pleurotus cystidiosus, and Schizophyllum commune as a potential source of functional lipids. Moreover, submerged cultivation was utilized for the production of mycelia and compounds with biological activities, including endopolysaccharides, exopolysaccharides, and ganoderic acids of G. lucidum [11]. Accordingly, this cultivation technique can be used to standardize the mycelial biomass production as well as the nutritive values and pharmacological properties of mushrooms.
In our interest to improve the mycelial biomass production and bioactivity and to address the low biological efficiency in solid-fermentation condition, this research had its main objective to determine the effect of time-course submerged culture on the mycelial production and functional properties (antioxidant, antibacterial, and cytotoxic) of P. sanguineus. The mycochemical constituents of the mycelia were also elucidated.
P. sanguineus (BIL7137) culture was acquired from the Bioassay Laboratory, Department of Biological Sciences, Central Luzon State University, Science City of Munoz, Nueva Ecija, Philippines. The cell line of this wild mushroom strain was rescued from Lingap Kalikasan Park in the same university. An agar block of mycelia was aseptically inoculated onto a sterilized potato dextrose agar (PDA) plate and incubated at 30°C for 7 days. A 10 mm-diameter cork borer was used to prepare mycelial disks as inoculant.
Coconut water from mature Cocos nucifera L. was used as a culture medium in the evaluation of mycelial biomass production in submerged culture. A 50 ml medium was dispensed into each 250 ml-capacity glass culture bottles with cotton plugged and sterilized at 15 psi, 121°C for 20 min. Each treatment was replicated 10 times. Bottled media were inoculated with mycelial disks and incubated at different periods at 30°C and static conditions in an incubation chamber. After incubation, the mycelia were harvested, air-dried, and weighed, and the culture spent volume was also recorded. The concentration of mycelial biomass was calculated by the ratio between mycelia (dry weight) and the volume of the medium used. The specific growth rate was also determined by computing for the natural log of the biomass (lnX) plotted against the fermentation time (t). For any given moment, the slope of the line gives the specific growth rate. Mycelia were pulverized using a food processor and extracted for the assays.
Three grams of pulverized mycelia from each incubation period were soaked in 300 ml of 80% ethanol for 48 h and filtered using No. 2 Whatman filter. Filtrates were concentrated to dryness in a rotary evaporator, which yielded 10.0–13.5% extract on a dry weight basis. The extracts were used for analyses and assays.
The stable free radical 2,2’diphenyl-1-1picrylhydrazyl (DPPH) scavenging activity of the extracts was determined following the procedure described by Kolak et al. [12] with modifications. Catechin was used as the standard. Absorbance readings were determined at 517 nm using a UV VIS spectrophotometer (Spectrumlab 752S, Hinotek Instrument Co., LTD, China) and percentage radical scavenging activity was computed using this formula: %RSA = [(Acontrol – Asample) / Acontrol] × 100. However, the Folin-Ciocalteu method of Sunita and Dhananjay [13] was followed with modifications to estimate the phenolic content of the extracts. The absorbance was read at 760 nm using the same UV VIS spectrophotometer and the phenolic content was expressed as mg gallic acid equivalent (GAE)/g of sample.
Disk diffusion method was carried out to evaluate the antibacterial effects of the extracts. Escherichia coli and Staphylococcus aureus cultures were obtained from the National Institute of Molecular Biology and Biotechnology, University of the Philippines-Los Banos, Los Banos, Laguna, Philippines. Nutrient broth bacterial suspensions were prepared and the turbidity was compared to 0.5 McFarland standard to equal to approximately 1.5 × 108 bacterial cells/mL. A 0.5 mL of bacterial suspension was inoculated and spread on Mueller-Hinton agar plate. Six mm-diameter paper disks impregnated with 20 μL of mushroom extract and streptomycin were equidistantly placed on the inoculated medium and subsequently incubated at 37°C. Each treatment was replicated three times in triplicate tests. After 24 h of incubation, zones of inhibition were measured.
Artemia salina lethality assay of Olowa and Nuñeza [14] was carried out to assess the cytotoxic effects of the mushroom extracts. The brine shrimps were acquired from the Bureau of Fisheries and Aquatic Resources-National Freshwater Fisheries Technology Center in the Philippines. Extracts at different concentrations (μg/mL) were prepared in triplicate vials. Ten nauplii were exposed into each vial for 24 h and the percentage mortality was recorded. The LC50 values were determined using probit analysis to determine the cytotoxicity level based on the established Clarkson et al. [15] toxicity index.
The mycochemicals present in the ethanol extract of mycelia from the cultures incubated for 25 days were screened following the protocol of Guevara [16]. The different mycochemicals were detected as spots in thin layer chromatography (TLC) through the use of UV light, hot plate, and several reagents used for a typical visualization of the secondary metabolites. Vanillin-sulfuric acid was used to determine the presence of phenols, sterols, fatty acids, triterpenes, and essential oil. Methanolic potassium hydroxide was used to visualize anthraquinones, coumarins, and anthrones, while potassium ferricyanide-ferric chloride was used to test phenolic compounds and tannins. Alkaloids and flavonoids were detected using Dragendorff’s reagent and antimony (III) chloride, respectively.
Analysis of variance (ANOVA) and Tukey’s honestly significant difference at 5% level of significance in the SAS System Version 9.0 was used to analyze and compare the data.
Mycelium is the vegetative structure of mushroom that could also be a source of biomass and bioactive compounds. Hence, evaluation of the biomass production of mushroom is indeed necessary. The production of mycelial biomass of P. sanguineus using coconut water as a culture medium at different periods of incubation was evaluated in this study. The fresh and dry weight of mycelia as affected by different incubation periods were determined (Table 1). The 25-day-old culture produced the highest yield (6.08 g fresh and 0.51 g dry), while the 10-day-old culture had the lowest. Statistically, the different periods of incubation significantly influenced the mycelial biomass production. It can be noticed that the mycelial biomass increased as the incubation period prolonged up to 25 days. The biomass concentration was computed and revealed that P. sanguineus incubated for 10 days produced 4.8 g/L of mycelial biomass and significantly increased up to 10.2 g/L as the incubation time extended up to 25 days with a specific growth rate of 0.640 g/L/day. These results strongly suggest that prolonged incubation can be a useful technique for mass production the mycelia, which could mask out the need for lengthy fruiting body production of mushrooms. Studies have found out the efficiency of prolonged incubation time to obtain higher mycelial yield in submerged culture condition. For instance, the wood ear mushroom, Auricularia polytricha, produced more cell mass as a time of fermentation extended to 20 days [17]. The same was also observed in the production mycelial biomass of a novel edible mushroom species, Lentinus tuberregium [18]. Contrastingly, the biomass production of three Auricularia species (A. delicata, A. polytricha, and A. auricula) in submerged fermentation in a longer incubation period of 30–40 days resulted to a decrease in the biomass yield [19]. They also added that the optimum incubation period for mycelial biomass production of the three Auricularia was 20–25 days. Therefore, it is too early to mention in the present study that 25 days was the optimum incubation period. Further investigation on the biomass production in the lengthier period of incubation is imperative to establish the maximum period of incubation.
Table 1: Mycelial biomass of P. sanguineus at different periods of incubation
| Incubation period (day) | Mycelial biomass (g) | Biomass concentration (g/L) | Specific growth rate (g/L/day) | |
|---|---|---|---|---|
| Fresh | Dry | |||
| 10 | 4.48±0.24b | 0.24±0.01d | 4.8 | 0.256 |
| 15 | 4.50±0.07b | 0.35±0.00c | 7.0 | 0.384 |
| 20 | 5.42±0.50a | 0.43±0.01b | 8.6 | 0.512 |
| 25 | 6.08±0.86a | 0.51±0.04a | 10.2 | 0.640 |
Values are expressed as mean±SEM (n=10). Means with the same letters of superscript are not significantly different from each other at 5% level of significance.
The morphology of mycelia as affected by the different periods of incubation was also observed (Figure 1). A 10-day-old culture had semi-transparent, very thin mycelia with white powder-like structures scattered on the top of mycelia (Figure 1a). These powder-like structures turned into light orange and the mycelia became thicker when incubated further up to 15 days (Figure 1b). After 20 days of incubation, the light orange mycelia became bright orange to red-orange with very thick mycelia (Figure 1c). Finally, at 25th day, the very thick mycelia produced pinkish to light orange massive primordia (Figure 1d). The high biomass yield in 20- and 25-day-old cultures is most likely attributed to the very thick mycelia and formation of primordia. The same cultural characteristics of P. sanguineus were also observed by Tellez-Tellez et al. [20]. They observed that the presence of salmon-red color or vermillion pigment becomes more intense as the mycelia aged, and they also believed that this characteristic greatly participates in bioactivities of the mycelia. Pigment characterization and biosynthesis revealed that phenoxazine-3-one type structure is the one accountable for the red color pigment of several Pycnoporus strains and for their bioactivities [20,21].
.png) | Figure 1: Mycelia of P. sanguineus grown in coconut water at different periods of incubation: (a) 10days, (b) 15 days, (c) 20 days, and (d) 25 days [Click here to view] |
The scavenging DPPH free radical assay can be utilized to analyze the antioxidant properties of compounds or extracts in a short time [22]. This work determined the radical scavenging activities of P. sanguineus mycelial extracts (Table 2). Notably, the extract of 25th-day mycelia recorded the highest scavenging activity of 37.25%, followed by 20th-day mycelial extract, which showed no statistical difference. In contrast, the lowest scavenging activity was noted in the extracts of early-harvested mycelia. These results suggest that the radical scavenging activity of P. sanguineus increased in extending time of incubation. Similarly, Borderes et al. [9] also investigated the effect of different time course in the radical scavenging activity of P. sanguineus mycelia harvested from 5th to 30th day (5 days interval) of incubation and they found out that as a time of incubation increased, the radical scavenging activity of the mycelia increased.
Table 2: Radical scavenging activity and phenolic content of ethanolic extracts of P. sanguineus mycelia grown at different periods of incubation.
| Extract of mycelia grown after | Radical scavenging activity (%) | Phenolic content (mg GAE/g sample) |
|---|---|---|
| 10 days | 31.69c | 73.89d |
| 15 days | 31.44c | 78.17c |
| 20 days | 36.62b | 86.29a |
| 25 days | 37.25b | 81.50b |
| Catechin | 72.10a | --- |
Values are expressed as mean (n=3). Means with the same letters of superscript are not significantly different from each other at 5% level of significance.
Phenolics represent the main antioxidant component in mushroom [23,24]. Phenolic antioxidants transfer hydrogen atom to peroxyl radicals and then converting them to hydroperoxides [25]. Thus, it was also quantified in this work (Table 2). Noticeably, extract of 20-day-old mycelia contained the highest of phenolic content (86.29 mg GAE/g sample), whereas 10-day-old mycelial extract registered the lowest (78.89 mg GAE/g sample). Our results conform with the study of Sanchez [26], who reported the presence of phenolic antioxidant compounds in P. sanguineus. Moreover, the phenolic contents obtained in the present work are higher than the phenolic contents of other edible mushrooms, including Ganoderma applanatum, Ganoderma lucidum, Schizophyllum commune, Auricularia auricula-judae, Lentinus tigrinus, Pleurotus ostreatus, and Pleurotus sajor-caju [27].
It is noteworthy to mention that 20-day-old mycelia, which had the highest phenolic content, was not the optimum mycelial age for radical scavenging activity. The high scavenging activity of 25-day-old mycelia, despite the lower phenolic content, could be attributed to non-phenolic antioxidants such as triterpene, anthrones, steroids, and other fatty acids, which are found present in mycochemical screening of the mycelia of P. sanguineus. Huang et al. [28] disclosed that the total phenolic content and the radical scavenging activity of the extracts are sometimes indirectly correlated. Based on the results, it is safe to conclude that P. sanguineus mycelia cultured for 20 days can be a sweet spot in obtaining phenolic-rich components.
Mushrooms have their own fighting mechanism for their competitor (e.g., bacteria). One of these mechanisms is by secreting compounds that contribute to the antimicrobial potential. The antibacterial activity of P. sanguineus mycelia ethanolic extract against E. coli and S. aureus was also studied (Table 3). All extracts of mycelia exhibited antibacterial activity against both bacteria. S. aureus was found to be more sensitive on the extract having a range of 8.00–9.30 mm diameter zone of inhibition. However, E. coli showed sensitivity ranging from 7.11 to 7.38 mm diameter zone of inhibition. The zones of inhibition exhibited by the extract of 25-day-old mycelia against the two bacteria are shown in Figure 2. Although extract from 10-day-old mycelia showed the widest diameter zone of inhibition in both bacteria, the difference of all mycelial extracts was statistically not significant. Therefore, we cannot presume that the antibacterial agents are most likely developed and produced at the younger stage of mycelia. However, the presence of the zone of inhibition strongly suggests the promising antibacterial potential of mycelial extract of P. sanguineus.
Table 3: Diameter of zone of inhibition of ethanolic extract of mycelia of P. sanguineus against S. aureus and E. coli.
| Extract of mycelia grown after | Diameter of zone of inhibition (mm) | |
|---|---|---|
| Staphylococcus aureus | Escherichia coli | |
| 10 days | 9.30±0.58b | 7.38±0.08b |
| 15 days | 8.00±0.44c | 7.11±0.28b |
| 20 days | 9.05±0.49b | 7.25±0.22b |
| 25 days | 8.12±0.16c | 7.34±0.06b |
| Streptomycin | 28.27±0.98a | 27.57±0.40a |
| Ethanol | 6.00±0.00d | 6.00±0.00c |
Values are expressed as mean±SEM (n=3). Means with the same letters of superscript are not significantly different from each other at 5% level of significance.
| Figure 2: Antibacterial assay plates showing the zones of inhibition exhibited by the mycelial extract of 25-day old culture of P. saguineus against (a) S. aureus and (b) E. coli. (E) mycelial extract, (+) streptomycin and (-) ethanol [Click here to view] |
In a similar study, a significant increase in antibacterial activity of Polyporus tricholoma against S. aureus was found in the extract of later harvest mycelia [29]. P. sanguineus has been reported to possess an excellent antibacterial property, particularly cinnabarin, which is usually extracted by ethyl acetate [30]. Moreover, the antibacterial property of P. sanguineus could be accounted to the present mycochemicals such as triterpenes, tannins, steroids, alkaloids, anthraquinones, and anthrones which are known to exhibit antibacterial properties.
A brine shrimp lethality assay was used as an indicator for broad toxicity. This is one of the important tools for the isolation of bioactive compounds [14]. Our paper is the first one to report the cytotoxic activity of P. sanguineus mycelia using this assay. Results of the assay showed that the mortality of brine shrimp nauplii increased as the concentrations of all mycelial extracts increased. Table 4 presents the computed LC50 values of the four extracts. Noticeably, the LC50 values of mycelial extracts decreased as the time of incubation in submerged culture prolonged, indicating that prolonging the incubation period could contribute to the toxicity of the mycelia. Interestingly, the obtained LC50 value of the 25-day-old mycelial extract is lower than the reported LC50 value (16.30 μg/mL) of cyclophosphamide, a commercially available anticancer drug [31]. This clearly suggests that P. sanguineus mycelia could be a valuable source of toxic compounds, which could be a potential anticancer drug.
Table 4: LC50 values and toxicity levels of ethanolic extracts of mycelia of P. sanguineus on brine shrimp nauplii after 24 h of exposure.
| Extract of mycelia grown after | LC50 (µg/mL) | Toxicity Levela |
|---|---|---|
| 10 days | 154.83 | Medium toxic |
| 15 days | 90.45 | Highly toxic |
| 20 days | 33.50 | Highly toxic |
| 25 days | 16.02 | Highly toxic |
Based on the cytotoxicity level established by Clarkson et al. [15]
In the interest of knowing the different mycochemicals that contributed to the different bioactivities of P. sanguineus mycelial extract, a thin-layer chromatography (TLC) spot test was carried out. The term mycochemical refers to a classification system of different mycological chemicals which are present or detected. These are chemicals that fungi, particularly mushrooms, produce to perform metabolic functions and also to protect themselves [4]. Due to the notable performance of 25-day-old mycelia of P. sanguineus, this was considered in the mycochemical screening. Nine mycochemicals were detected including triterpenes, flavonoids, tannins, phenols, steroids, alkaloids, anthraquinones, anthrones, and fatty acids. Several studies reported the biological activities of the above-mentioned mycochemicals.
Triterpenes have antibacterial, antifungal, antiviral, anti-inflammatory, anti-oxidative, and anticancer properties [32]. Zuco et al. [33] stated that among the bioactive compounds, triterpenes showed low activity in normal cells but cytotoxic against tumor cells. Flavonoids are known for their antioxidant property, anticarcinogenesis potential, antiproliferative effects against cancer cell lines, and also chemopreventive agent [34]. Tannins are astringent, bitter polyphenols that are reported to have a major impact on animal nutrition due to their ability to bind to protein and other macromolecules and also has antioxidant properties [35]. Phenols are under an important class of antioxidants that reduce the oxidative degradation of organic materials [36]. Steroids are known to be important for their cardiotonic activities and also possess insecticidal, antioxidant activity, and antimicrobial properties [37].
Alkaloids are found to have significant antibacterial and antifungal activities, have allelopathically active chemicals, and a possibility to have a cytotoxic effect [38]. Anthraquinones are known to be laxative compounds for constipation. They have cathartic and diuretic effects, anti-inflammatory, anticancer, antimicrobial, vasorelaxant activities and DNA binding ability. Recently anthraquinones are discovered to have therapeutic potential on autoimmune diabetes [39]. Anthrones possess antibacterial, antifungal, antioxidant, and anti-inflammatory properties [40]. Fatty acids, especially polyunsaturated ones, the omega-3 and omega-6 series, are essential in the human health for preventing physiologically-related diseases and autoimmune disorders. Fatty acids are also much needed in one’s diet [41].
Collectively, this paper demonstrated the time-course submerged cultivation of mycelial biomass and its effects on the biological activities of P. sanguineus. A prolonged incubation up to 25 days enhances the mycelial production and improves antioxidant activity and toxicity. However, the antibacterial property is not affected by the periods of incubation. The 25-day-old mycelia contain a variety of mycochemicals, which are responsible to the antioxidant and antibacterial activities, and toxic effect exhibited in the present study, and most likely to other biological activities of P. sanguineus mycelia, which we need to further elucidate.
Authors declared that they do not have any conflicts of interest.
None.
1. Dulay RM, Pamiloza DG. Proximate composition and bioactivities of hairy sawgill mushroom, Lentinus strigosus (BIL 1324) from the Philippines. Int J Biol Pharm Allied Sci 2018;7:361-9. [CrossRef]
2. Aquino YK, Vega LD, Medrano NR, Dulay RM. Mycochemicals, antioxidant and cytotoxic activities of Polyporus grammocephalus Berk (BIL7749). Int J Biol Pharm Allied Sci 2018;7:966-75. [CrossRef]
3. Dulay RM, Arenas MC, Kalaw SP, Reyes RG, Cabrera EC. Proximate composition and functionality of the culinary-medicinal tiger sawgill mushroom, Lentinus tigrinus (higher basidiomycetes), from the Philippines. Int J Med Mushrooms 2014;16:85-94. [CrossRef]
4. Dulay RM, Kalaw SP, Reyes RG, Cabrera EC. Embryo-toxic and teratogenic effects of Philippine strain of Lentinus tigrinus (tiger sawgill basidiomycetes) extract on zebrafish (Danio rerio) embryos. Ann Biol Res 2014;5:9-14.
5. Dulay RM, Miranda LA, Malasaga JS, Kalaw SP, Reyes RG, Hou CT. Antioxidant and antibacterial activities of acetonitrile and hexane extracts of Lentinus tigrinus and Pleurotus djamor. Biocatal Agric Biotechnol 2017;9:141-4. [CrossRef]
6. Menaga D, Ayyasamy PM. Effect of horse gram on the cultivation of Pleurotus florida mushroom and their phytochemical analysis and antimicrobial activity. Int J Res Pharm Sci 2012;3:140-5.
7. Yahaya YA, Mashitah MD. Pycnoporus sanguineus as potential biosorbent for heavy metal removal from aqueous solution: A review. J Phys Sci 2014;25:1-32.
8. Baumer JD, Mas Diego SM, Pacheco SM, Morgado AF, Furigo AF Jr. Comparative study of mycelial growth and production of cinnabarin by different strains of Pycnoporus sanguineus. Rev Biol Farm 2008;2:1-5.
9. Borderes J, Costa A, Guedes A, Tavares LB. Antioxidant activity of the extracts from Pycnoporus sanguineus mycelium. Braz Arch Biol Technol 2011;54:1167-74. [CrossRef]
10. Dulay RM, Ray K, Hou CT. Optimization of liquid culture conditions of Philippine wild edible mushrooms as potential source of bioactive lipids. Biocatal Agric Biotechnol 2015;4:409-15. [CrossRef]
11. Wagner R, Mitchell DA, Sassaki GL, Amazonas MA, Berovic M. Current techniques for the cultivation of Ganoderma lucidum for the production of biomass, ganoderic acid and polysaccharides. Food Technol Biotechnol 2003;41:371-82.
12. Kolak U, Öztürk M, Özgökçe F, Ulubelen A. Norditerpene alkaloids from Delphinium linearilobum and antioxidant activity. Phytochemistry 2006;67:2170-5. [CrossRef]
13. Sunita M, Dhananjay S. Quantitative analysis of total phenolics content in Adhatoda vasica Nees extracts. Int J PharmTech Res 2010;2:2403-6.
14. Olowa LF, Nuñeza OM. Brine shrimp lethality assay of the ethanolic extracts of three selected species of medicinal plants from Iligan City, Philippines. Int Res J Biol Sci 2013;2:74-7.
15. Clarkson C, Maharaj VJ, Crouch NR, Grace OM, Pillay P, Matsabisa MG, et al. In vitro antiplasmodial activity of medicinal plants native to or naturalized in South Africa. J Ethnopharmacol 2004;92:177-91. [CrossRef]
16. Guevara B. A Guidebook to Plant Screening: Phytochemical and Biological. Manila, Philippines: UST Publishing House; 2005.
17. Hassan FR, Medany GM. Studies on submerged culture conditions for mycelial biomass production of wood ears mushroom (Auricularia polytricha). Middle East J Agric Res 2012;1:33-9.
18. Gupta N, Behera S, Dash S. Effect of culture conditions on radial growth, submerged biomass and moisture content of Lentinus tuberregium, a new edible mushroom. Appl Sci Rep 2015;11:106-9. [CrossRef]
19. Devi MB, Singh SM, Singh NI. Biomass production in Auricularia spp. (Jew's ear) collected from Manipur, India. Int J Curr Microbiol Appl Sci 2015;4:985-9.
20. Téllez-Téllez M, Villegas E, Rodríguez A, Acosta-Urdapilleta ML, O'Donovan A, Díaz-Godínez G. Mycosphere essay 11: Fungi of Pycnoporus genus: Morphological and molecular identification, worldwide distribution and biotechnological potential. Mycosphere 2016;7:1500-25. [CrossRef]
21. Achenbach H, Blümm E. Investigation of the pigments of Pycnoporus sanguineus-pycnosanguin and new phenoxazin-3-ones. Arch Pharm 1991;324:3-6. [CrossRef]
22. Cheung LM, Cheung PC, Ooi VE. Antioxidant activity and total phenolics of edible mushroom extracts. Food Chem 2003;81:249-55. [CrossRef]
23. Vamanu E. In vitro antimicrobial and antioxidant activities of ethanolic extract of lyophilized mycelium of Pleurotus ostreatus PQMZ91109. Molecules 2012;17:3653-71. [CrossRef]
24. Barros L, Ferreira MJ, Queirós B, Ferreira IC, Baptista P. Total phenols, ascorbic acid, ?-carotene and lycopene in Portuguese wild edible mushrooms and their antioxidant activities. Food Chem 2007;103:413-9. [CrossRef]
25. Barclay LR, Vinqvist MR. Phenols as Antioxidants: The Chemistry of Phenols. England: John Wiley & Sons Ltd.; 2003.
26. Sanchez C. Reactive oxygen species and antioxidant properties from mushrooms. Synth Syst Biotechnol 2016;2:13-22. [CrossRef]
27. Prasad R, Varshney VK, Harsh NS, Kumar M. Antioxidant capacity and total phenolics content of the fruiting bodies and submerged cultured mycelia of sixteen higher basidiomycetes mushrooms from India. Int J Med Mushrooms 2013;17:933-41. [CrossRef]
28. Huang D, Ou B, Prior RL. The chemistry behind antioxidant capacity assays. J Agric Food Chem 2005;53:1841-56. [CrossRef]
29. Vieira GR, Liebl M, Tavares LB, Paulert R, Smania Junior A. Submerged culture conditions for the production of mycelial biomass and antimicrobial metabolites by Polyporus tricholoma Mont. Braz J Microbiol 2008;39:561-8. [CrossRef]
30. Albino SE, Junior AS, Loguercio-Leite C. Cinnabarin synthesis by Pycnoporus sanguineus strains and antimicrobial activity against bacteria from food products. Rev Microbiol 1998;29:317-20. [CrossRef]
31. Moshi MJ, Innocent E, Magadula JJ, Otieno DF, Weisheit A, Mbabazi PK, et al. Brine shrimp toxicity of some plants used as traditional medicines in Kagera region, North Western Tanzania. Tanzan J Health Res 2010;12:63-7. [CrossRef]
32. Chudzik M, Korzonek-Szlacheta I, Król W. Triterpenes as potentially cytotoxic compounds. Molecules 2015;20:1610-25. [CrossRef]
33. Zuco V, Supino R, Righetti SC, Cleris L, Marchesi E, Gambacorti-Passerini C, et al. Selective cytotoxicity of betulinic acid on tumor cell lines, but not on normal cells. Cancer Lett 2002;175:17-25. [CrossRef]
34. Lin JK, Weng MS. Flavonoids as Nutraceuticals. United States: Springer Science+Business Media Inc.; 2006. [CrossRef]
35. Ashok PK, Upadhyaya K. Tannins are astringent. J Pharmacogn Phytochem 2012;1:45-50.
36. Nguyen MT, Kryachko ES, Vanquickenborne LG. General and Theoretical Aspects of Phenols: The Chemistry of Phenols. England: John Wiley & Sons Ltd.; 2003.
37. Nanglihan KE, Dulay RM, Kalaw SP. Myko-actives and functional activities of Philippine wild mushroom Trametes elegans. Int J Biosci 2018;13:402-8. [CrossRef]
38. Saxena M, Saxena J, Nema R, Singh D, Gupta A. Phytochemistry of medicinal plants. J Pharmacogn Phytochem 2013;1:168-82.
39. Chien SC, Wu YC, Chen ZW, Yang WC. Naturally occurring anthraquinones: Chemistry and therapeutic potential in autoimmune diabetes. Evid Based Complement Altern Med 2015;2015:357357. [CrossRef]
40. Asamenew G, Bisrat D, Mazumder A, Asres K. In vitro antimicrobial and antioxidant activities of anthrone and chromone from the latex of Aloe harlana reynolds. Phytother Res 2011;25:1756-60. [CrossRef]
41. Cayan F, Tel-Cayan G, Ozler MA, Duru ME. Comparative study of fatty acids profile of wild mushroom species from Turkey. Eurasian J Anal Chem 2017;12:257-63. [CrossRef]
1. Dulay RM, Pamiloza DG. Proximate composition and bioactivities of hairy sawgill mushroom, Lentinus strigosus (BIL 1324) from the Philippines. Int J Biol Pharm Allied Sci 2018;7:361-9. https://doi.org/10.31032/IJBPAS/2018/7.3.4400 | |
2. Aquino YK, Vega LD, Medrano NR, Dulay RM. Mycochemicals, antioxidant and cytotoxic activities of Polyporus grammocephalus Berk (BIL7749). Int J Biol Pharm Allied Sci 2018;7:966-75. https://doi.org/10.31032/IJBPAS/2018/7.6.4455 | |
3. Dulay RM, Arenas MC, Kalaw SP, Reyes RG, Cabrera EC. Proximate composition and functionality of the culinary-medicinal tiger sawgill mushroom, Lentinus tigrinus (higher basidiomycetes), from the Philippines. Int J Med Mushrooms 2014;16:85-94. https://doi.org/10.1615/IntJMedMushr.v16.i1.80 | |
4. Dulay RM, Kalaw SP, Reyes RG, Cabrera EC. Embryo-toxic and teratogenic effects of Philippine strain of Lentinus tigrinus (tiger sawgill basidiomycetes) extract on zebrafish (Danio rerio) embryos. Ann Biol Res 2014;5:9-14. | |
5. Dulay RM, Miranda LA, Malasaga JS, Kalaw SP, Reyes RG, Hou CT. Antioxidant and antibacterial activities of acetonitrile and hexane extracts of Lentinus tigrinus and Pleurotus djamor. Biocatal Agric Biotechnol 2017;9:141-4. https://doi.org/10.1016/j.bcab.2016.12.003 | |
6. Menaga D, Ayyasamy PM. Effect of horse gram on the cultivation of Pleurotus florida mushroom and their phytochemical analysis and antimicrobial activity. Int J Res Pharm Sci 2012;3:140-5. | |
7. Yahaya YA, Mashitah MD. Pycnoporus sanguineus as potential biosorbent for heavy metal removal from aqueous solution: A review. J Phys Sci 2014;25:1-32. | |
8. Baumer JD, Mas Diego SM, Pacheco SM, Morgado AF, Furigo AF Jr. Comparative study of mycelial growth and production of cinnabarin by different strains of Pycnoporus sanguineus. Rev Biol Farm 2008;2:1-5. | |
9. Borderes J, Costa A, Guedes A, Tavares LB. Antioxidant activity of the extracts from Pycnoporus sanguineus mycelium. Braz Arch Biol Technol 2011;54:1167-74. https://doi.org/10.1590/S1516-89132011000600012 | |
10. Dulay RM, Ray K, Hou CT. Optimization of liquid culture conditions of Philippine wild edible mushrooms as potential source of bioactive lipids. Biocatal Agric Biotechnol 2015;4:409-15. https://doi.org/10.1016/j.bcab.2015.04.003 | |
11. Wagner R, Mitchell DA, Sassaki GL, Amazonas MA, Berovic M. Current techniques for the cultivation of Ganoderma lucidum for the production of biomass, ganoderic acid and polysaccharides. Food Technol Biotechnol 2003;41:371-82. | |
12. Kolak U, Öztürk M, Özgökçe F, Ulubelen A. Norditerpene alkaloids from Delphinium linearilobum and antioxidant activity. Phytochemistry 2006;67:2170-5. https://doi.org/10.1016/j.phytochem.2006.06.006 | |
13. Sunita M, Dhananjay S. Quantitative analysis of total phenolics content in Adhatoda vasica Nees extracts. Int J PharmTech Res 2010;2:2403-6. | |
14. Olowa LF, Nuñeza OM. Brine shrimp lethality assay of the ethanolic extracts of three selected species of medicinal plants from Iligan City, Philippines. Int Res J Biol Sci 2013;2:74-7. | |
15. Clarkson C, Maharaj VJ, Crouch NR, Grace OM, Pillay P, Matsabisa MG, et al. In vitro antiplasmodial activity of medicinal plants native to or naturalized in South Africa. J Ethnopharmacol 2004;92:177-91. https://doi.org/10.1016/j.jep.2004.02.011 | |
16. Guevara B. A Guidebook to Plant Screening: Phytochemical and Biological. Manila, Philippines: UST Publishing House; 2005. | |
17. Hassan FR, Medany GM. Studies on submerged culture conditions for mycelial biomass production of wood ears mushroom (Auricularia polytricha). Middle East J Agric Res 2012;1:33-9. | |
18. Gupta N, Behera S, Dash S. Effect of culture conditions on radial growth, submerged biomass and moisture content of Lentinus tuberregium, a new edible mushroom. Appl Sci Rep 2015;11:106-9. https://doi.org/10.15192/PSCP.ASR.2015.11.3.106109 | |
19. Devi MB, Singh SM, Singh NI. Biomass production in Auricularia spp. (Jew's ear) collected from Manipur, India. Int J Curr Microbiol Appl Sci 2015;4:985-9. | |
20. Téllez-Téllez M, Villegas E, Rodríguez A, Acosta-Urdapilleta ML, O'Donovan A, Díaz-Godínez G. Mycosphere essay 11: Fungi of Pycnoporus genus: Morphological and molecular identification, worldwide distribution and biotechnological potential. Mycosphere 2016;7:1500-25. https://doi.org/10.5943/mycosphere/si/3b/3 | |
21. Achenbach H, Blümm E. Investigation of the pigments of Pycnoporus sanguineus-pycnosanguin and new phenoxazin-3-ones. Arch Pharm 1991;324:3-6. https://doi.org/10.1002/ardp.19913240103 | |
22. Cheung LM, Cheung PC, Ooi VE. Antioxidant activity and total phenolics of edible mushroom extracts. Food Chem 2003;81:249-55. https://doi.org/10.1016/S0308-8146(02)00419-3 | |
23. Vamanu E. In vitro antimicrobial and antioxidant activities of ethanolic extract of lyophilized mycelium of Pleurotus ostreatus PQMZ91109. Molecules 2012;17:3653-71. https://doi.org/10.3390/molecules17043653 | |
24. Barros L, Ferreira MJ, Queirós B, Ferreira IC, Baptista P. Total phenols, ascorbic acid, β-carotene and lycopene in Portuguese wild edible mushrooms and their antioxidant activities. Food Chem 2007;103:413-9. https://doi.org/10.1016/j.foodchem.2006.07.038 | |
25. Barclay LR, Vinqvist MR. Phenols as Antioxidants: The Chemistry of Phenols. England: John Wiley & Sons Ltd.; 2003. | |
26. Sanchez C. Reactive oxygen species and antioxidant properties from mushrooms. Synth Syst Biotechnol 2016;2:13-22. https://doi.org/10.1016/j.synbio.2016.12.001 | |
27. Prasad R, Varshney VK, Harsh NS, Kumar M. Antioxidant capacity and total phenolics content of the fruiting bodies and submerged cultured mycelia of sixteen higher basidiomycetes mushrooms from India. Int J Med Mushrooms 2013;17:933-41. https://doi.org/10.1615/IntJMedMushrooms.v17.i10.30 | |
28. Huang D, Ou B, Prior RL. The chemistry behind antioxidant capacity assays. J Agric Food Chem 2005;53:1841-56. https://doi.org/10.1021/jf030723c | |
29. Vieira GR, Liebl M, Tavares LB, Paulert R, Smania Junior A. Submerged culture conditions for the production of mycelial biomass and antimicrobial metabolites by Polyporus tricholoma Mont. Braz J Microbiol 2008;39:561-8. https://doi.org/10.1590/S1517-83822008000300029 | |
30. Albino SE, Junior AS, Loguercio-Leite C. Cinnabarin synthesis by Pycnoporus sanguineus strains and antimicrobial activity against bacteria from food products. Rev Microbiol 1998;29:317-20. https://doi.org/10.1590/S0001-37141998000400017 | |
31. Moshi MJ, Innocent E, Magadula JJ, Otieno DF, Weisheit A, Mbabazi PK, et al. Brine shrimp toxicity of some plants used as traditional medicines in Kagera region, North Western Tanzania. Tanzan J Health Res 2010;12:63-7. https://doi.org/10.4314/thrb.v12i1.56287 | |
32. Chudzik M, Korzonek-Szlacheta I, Król W. Triterpenes as potentially cytotoxic compounds. Molecules 2015;20:1610-25. https://doi.org/10.3390/molecules20011610 | |
33. Zuco V, Supino R, Righetti SC, Cleris L, Marchesi E, Gambacorti- Passerini C, et al. Selective cytotoxicity of betulinic acid on tumor cell lines, but not on normal cells. Cancer Lett 2002;175:17-25. https://doi.org/10.1016/S0304-3835(01)00718-2 | |
34. Lin JK, Weng MS. Flavonoids as Nutraceuticals. United States: Springer Science+Business Media Inc.; 2006. https://doi.org/10.1007/978-0-387-28822-2_8 | |
35. Ashok PK, Upadhyaya K. Tannins are astringent. J Pharmacogn Phytochem 2012;1:45-50. | |
36. Nguyen MT, Kryachko ES, Vanquickenborne LG. General and Theoretical Aspects of Phenols: The Chemistry of Phenols. England: John Wiley & Sons Ltd.; 2003. | |
37. Nanglihan KE, Dulay RM, Kalaw SP. Myko-actives and functional activities of Philippine wild mushroom Trametes elegans. Int J Biosci 2018;13:402-8. https://doi.org/10.12692/ijb/13.5.402-408 | |
38. Saxena M, Saxena J, Nema R, Singh D, Gupta A. Phytochemistry of medicinal plants. J Pharmacogn Phytochem 2013;1:168-82. | |
39. Chien SC, Wu YC, Chen ZW, Yang WC. Naturally occurring anthraquinones: Chemistry and therapeutic potential in autoimmune diabetes. Evid Based Complement Altern Med 2015;2015:357357. https://doi.org/10.1155/2015/357357 | |
40. Asamenew G, Bisrat D, Mazumder A, Asres K. In vitro antimicrobial and antioxidant activities of anthrone and chromone from the latex of Aloe harlana reynolds. Phytother Res 2011;25:1756-60. https://doi.org/10.1002/ptr.3482 | |
41. Cayan F, Tel-Cayan G, Ozler MA, Duru ME. Comparative study of fatty acids profile of wild mushroom species from Turkey. Eurasian J Anal Chem 2017;12:257-63. https://doi.org/10.12973/ejac.2017.00168a | |
Year
Month
Statistical optimization of culture conditions for enhanced mycelial biomass production using Ganoderma lucidum
Pooja Shah, Hasmukh ModiThe propensity of selected Indian plant extracts for polyphenolics, antioxidant, and inhibition of Pseudomonas aeruginosa biofilms through type-3 secretion system
M. G. Avinash, Farhan Zameer,, Shubha GopalThe medicinal plant Berberis aristata and its endophytes for pharmacological applications: Current research and future challenges
Sheetal Sharma, M. V. N. L. Chaitanya, Sarika Sharma, Sanjeev Kumar, Sarvesh Rustagi, Sangram Singh, Sheikh Shreaz, Ashutosh Kumar Rai, Rajeshwari Negi, Ajar Nath Yadav,